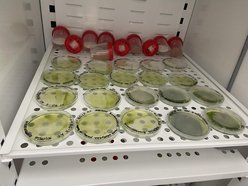
Łódź. Bioreaktor na Politechnice Łódzkiej. Czy mikroglony z rzek i stawów w Łodzi uratują nasze powietrze?

Często szukamy ratunku dla klimatu w sadzeniu drzew, zapominając, że prawdziwi rekordziści w produkcji tlenu są niemal niewidoczni. Mikroglony, bo o nich mowa, odpowiadają za wytworzenie nawet 80% tlenu w ziemskiej atmosferze. To właśnie te mikroskopijne organizmy stały się fundamentem innowacyjnego bioreaktora budowanego przez studentów z Koła Naukowego AlgoTech.
Lokalni bohaterowie w szklanych rurach
To, co wyróżnia projekt GLO2xygen, to jego „łódzkie DNA”. Zamiast kupować egzotyczne szczepy alg z odległych zakątków świata, młodzi naukowcy sięgnęli po to, co mamy pod ręką. W sercu instalacji zamieszkają izolaty z rodzajów Chlorella oraz Tetradesmus, pozyskane bezpośrednio z łódzkich zbiorników wodnych.
– Nasze mikroglony są już naturalnie przystosowane do lokalnego klimatu. To sprawia, że są twardsze i bardziej wydajne w walce o lepszy mikroklimat na kampusie – tłumaczą twórcy projektu. Dzięki intensywnej fotosyntezie, te małe „fabryki” z ogromną skutecznością pochłaniają dwutlenek węgla, oddając w zamian czysty tlen.
Od pomysłu do technologicznego prototypu
Projekt wystartował w lutym 2026 roku i nie jest jedynie teoretycznym ćwiczeniem. To pełnoprawny proces inżynieryjny finansowany przez Fundację ORLEN w ramach programu TURBOgrant. Studenci Wydziału Biotechnologii i Nauk o Żywności samodzielnie projektują układ, budują konstrukcję i planują analizę danych.
Harmonogram prac jest ambitny:
- Testy laboratoryjne: Bioreaktor zostanie sprawdzony w kontrolowanych warunkach, by precyzyjnie zmierzyć jego wydajność,
- Debiut na kampusie: Po uzyskaniu stabilnej hodowli, instalacja trafi „w teren”, stając się częścią ekosystemu Politechniki, obok m.in. znanych już murali z farb fotokatalitycznych,
- Edukacja w praktyce: Bioreaktor ma służyć jako model demonstracyjny dla studentów i uczniów szkół średnich, pokazując, że przyszłość inżynierii jest zielona.